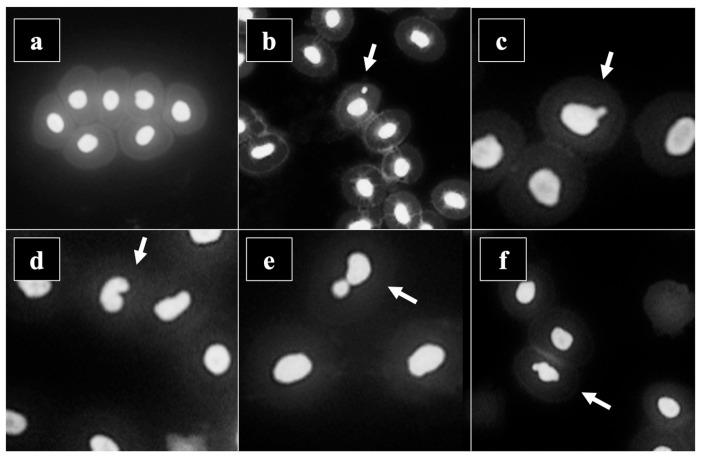
https://cdn.ncbi.nlm.nih.gov/pmc/blobs/8d11/11679168/36bb9d6d35b7/toxics-12-00849-g003.jpg

我们中间的外来者:外来入侵鱼类黑斑牛尾鱼作为污染生物指示物的敏感性及其对人类食用的安全性
Aliens Among Us: Sensitivity of the Invasive Alien Fish Black Bullhead as a Bioindicator of Pollution and Its Safety for Human Consumption.
作者信息
Kostić Jovana, Đorđević Aleksić Jelena, Višnjić-Jeftić Željka, Nikolić Dušan, Marković Zoran, Kračun-Kolarević Margareta, Tasić Aleksandra, Jaćimović Milica
机构信息
Department of Biology and Inland Waters Protection, Institute for Multidisciplinary Research, University of Belgrade, 11030 Belgrade, Serbia.
Department of Growing and Reproduction of Domestic and Raised Animals, Institute of Animal Science, Faculty of Agriculture, University of Belgrade, 11080 Belgrade, Serbia.
出版信息
Toxics. 2024 Nov 25;12(12):849. doi: 10.3390/toxics12120849.
This study aims to evaluate the black bullhead , an invasive alien fish (IAF) in Serbia, as a bioindicator organism and assess the safety of natural and aquaculture specimens for human consumption. A set of biomarkers was analysed to assess the bioindicator potential at a site exposed to agricultural activities. The genotoxic response was determined by an alkaline comet assay and micronucleus assay in fish erythrocytes, and the metal pollution index (MPI) was calculated to assess the toxic element burden on fish. Water quality was evaluated using physicochemical parameters and faecal indicator bacteria, while sediment was analysed for the presence of pesticides. The concentration of metals and metalloids in fish muscle was monitored to assess the safety for human consumption, and the corresponding indices (MAC, THQ, HI) were calculated. All biomarker responses were linked by the integrated biomarker response (IBR). Water analyses indicated the absence of communal wastewater, while sediment analysis revealed the presence of paclobutrazol, bifenthrin, and cyfluthrin. The IBR showed that June and September had the highest stress indices, coinciding with peak pesticide use and precipitation. All indices confirmed the safety of black bullhead for human consumption. This study highlighted the uses of nature-based solutions to the problem of IAF.
本研究旨在评估作为生物指示生物的黑斑牛尾鱼(一种塞尔维亚的外来入侵鱼类),并评估天然和水产养殖样本供人类食用的安全性。分析了一组生物标志物,以评估在受农业活动影响的地点的生物指示潜力。通过鱼红细胞中的碱性彗星试验和微核试验确定遗传毒性反应,并计算金属污染指数(MPI)以评估鱼类的有毒元素负荷。使用理化参数和粪便指示菌评估水质,同时分析沉积物中农药的存在情况。监测鱼肌肉中金属和类金属的浓度,以评估供人类食用的安全性,并计算相应指数(最大允许浓度、危害商数、健康指数)。所有生物标志物反应均通过综合生物标志物反应(IBR)联系起来。水质分析表明不存在城市污水,而沉积物分析显示存在多效唑、联苯菊酯和氯氟氰菊酯。IBR表明,6月和9月的应激指数最高,这与农药使用高峰和降水量相吻合。所有指数均证实黑斑牛尾鱼供人类食用是安全的。本研究强调了基于自然的解决方案在应对外来入侵鱼类问题方面的用途。